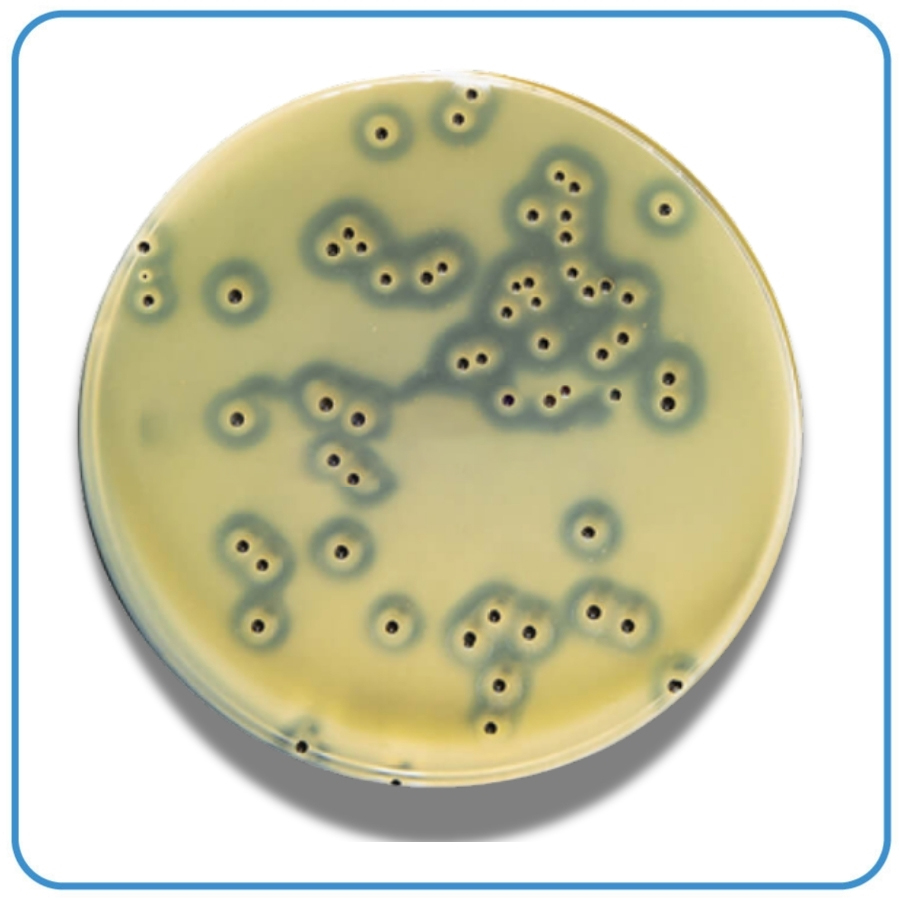
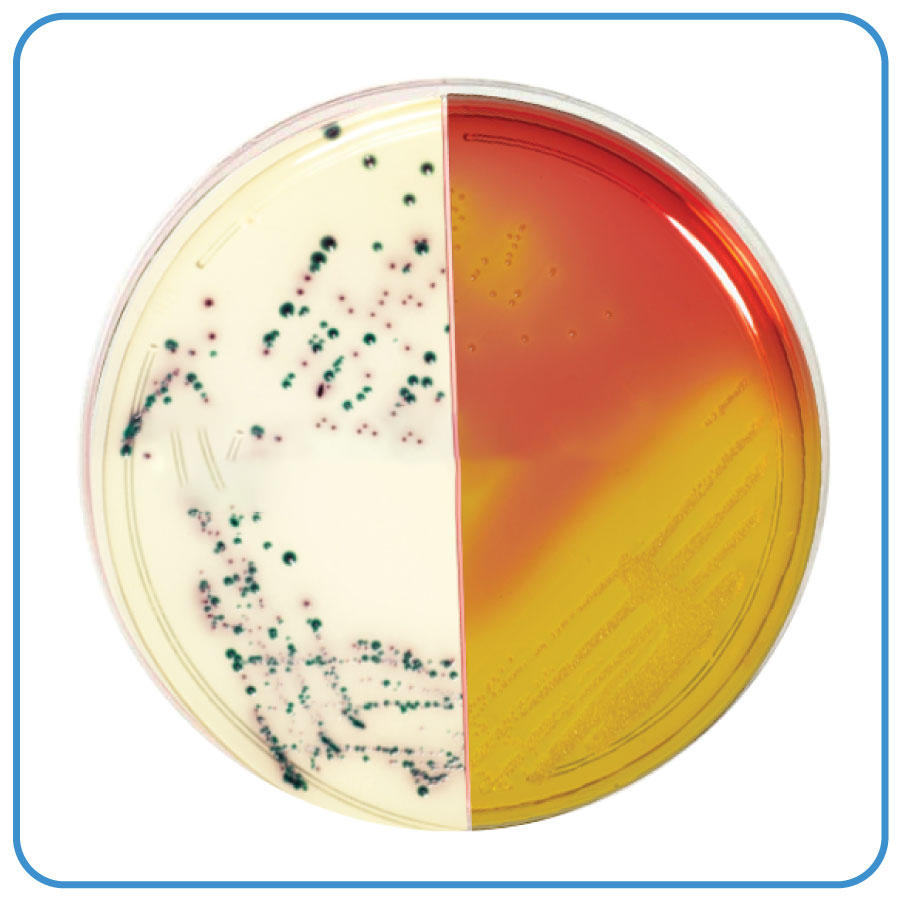
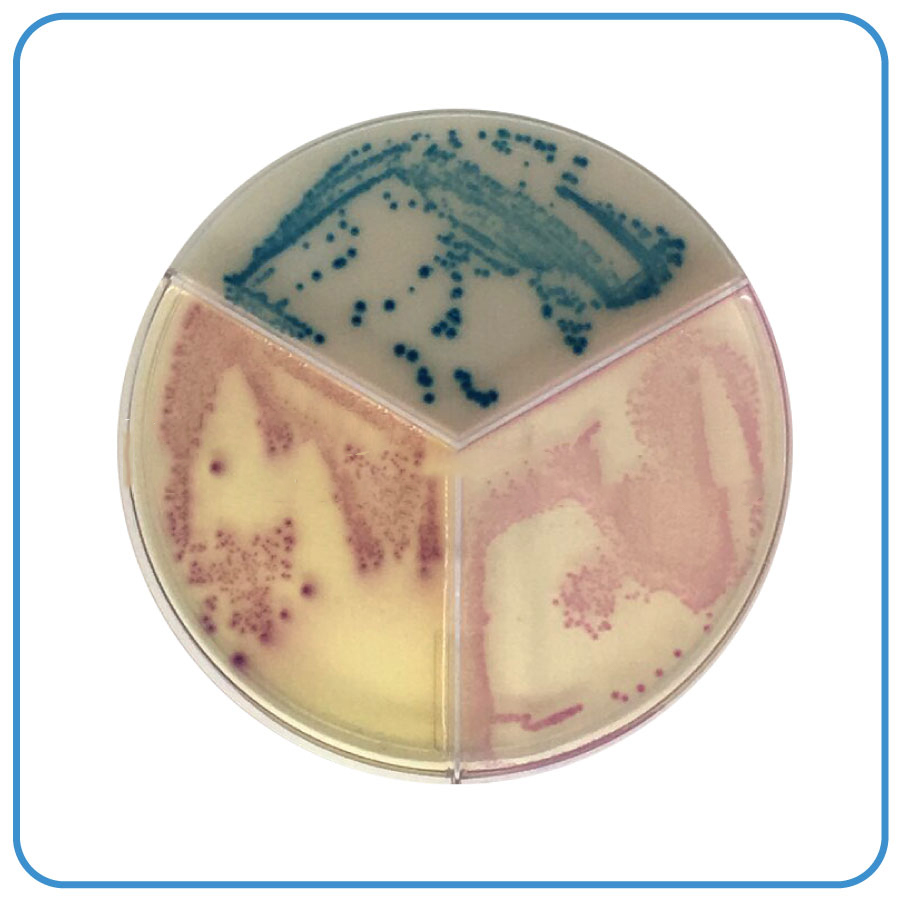

Môi trường nuôi cấy vi sinh vật là môi trường cung cấp các chất dinh dưỡng cần thiết cho sự phát triển, sinh trưởng và tăng sinh của vi sinh vật như vi khuẩn, nấm men, nấm mốc. Môi trường này giúp nghiên cứu và xác định các đặc tính sinh lý của vi sinh vật trong các thí nghiệm phòng thí nghiệm, mang lại kết quả chính xác và hiệu quả.